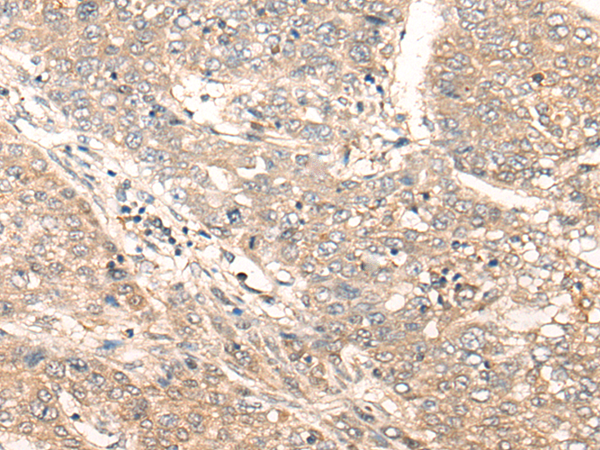
一抗

中文名稱: 兔抗ACER1多克隆抗體
英文名稱: Anti-ACER1 rabbit polyclonal antibody
別 名: ASAH3; ALKCDase1
儲 存: 冷凍(-20℃)
抗 原: ACER1
宿 主: Rabbit
反應(yīng)種屬: Human
相關(guān)類別: 一抗
標(biāo) 記 物: Unconjugate
克隆類型: rabbit polyclonal
技術(shù)規(guī)格
|
Background: |
Ceramides are synthesized during epidermal differentiation and accumulate within the interstices of the stratum corneum, where they represent critical components of the epidermal permeability barrier. Excess cellular ceramide can trigger antimitogenic signals and induce apoptosis, and the ceramide metabolites sphingosine and sphingosine-1-phosphate (S1P) are important bioregulatory molecules. Ceramide hydrolysis in the nucleated cell layers regulates keratinocyte proliferation and apoptosis in response to external stress. Ceramide hydrolysis also occurs at the stratum corneum, releasing free sphingoid base that functions as an endogenous antimicrobial agent. ACER1 is highly expressed in epidermis and catalyzes the hydrolysis of very long chain ceramides to generate sphingosine (Houben et al., 2006 [PubMed 16477081]; Sun et al., 2008 [PubMed 17713573]). |
|
Applications: |
ELISA, IHC |
|
Name of antibody: |
ACER1 |
|
Immunogen: |
Synthetic peptide of human ACER1 |
|
Full name: |
alkaline ceramidase 1 |
|
Synonyms: |
ASAH3; ALKCDase1 |
|
SwissProt: |
Q8TDN7 |
|
ELISA Recommended dilution: |
5000-10000 |
|
IHC positive control: |
Human liver cancer and human brain |
|
IHC Recommend dilution: |
25-100 |


 購物車
購物車 幫助
幫助
 021-54845833/15800441009
021-54845833/15800441009